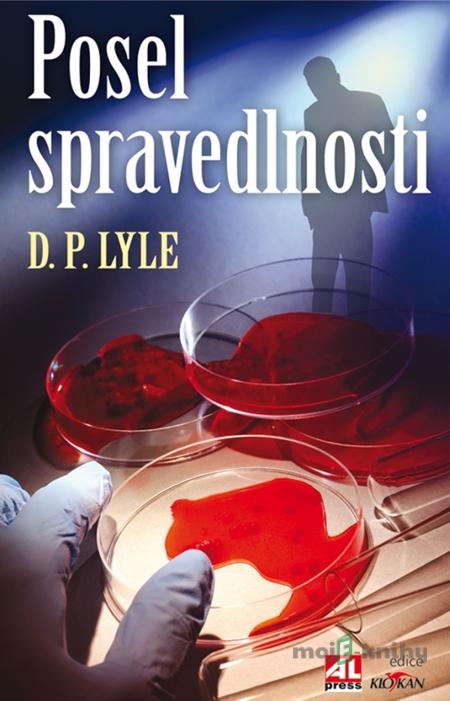
Posel spravedlnosti - Douglas Lyle Posel spravedlnosti - Douglas Lyle

Popis
Dub Walker vyšetřoval stovky zločinů, ohledával zohavené ostatky obětí brutálních vražd, a proto se domníval, že v jeho profesi ho už nic nepřekvapí. Ovšem když je zavražděn jeho blízký přítel, vše je jinak. Vrah jako by se mu vysmíval, jeho brutalita roste s každou další obětí. Walker nastraží na pachatele past, ale to, co v ní uvízne, mu doslova vyrazí dech…
Recenzie
Nikto zatiaľ nepridal hodnotenie.